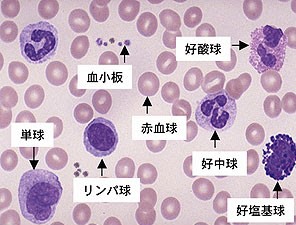
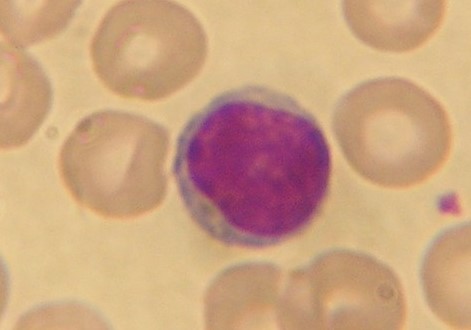

| はじめに |
お金は経済の血液だ、などと言われます。
お金によって、経済は順調に目まぐるしく回って行きます。
人間の身体も、全ての場所に血液が行き渡り、それで各臓器が十分な機能を発揮出来ることになります。
一見無関係に見える口腔機能と血液ですが、健全な血液が無ければ、口腔機能もその役目を果たせません。
ここでは、血液の基本と、口腔内での関係について述べさせて頂きます。
|
| 血液と血液の病気について |
血液の病気は数多くありますが、口腔機能に関わる基本的な病気だけ記載してみます。
GR:血液の機能および生理
1:赤血球とその働き
2:白血球とその働き
3:血小板とその働き
A:赤血球の異常 1:貧血 2:赤血球増多症 B:白血球の異常 1:顆粒球減少症 2:無顆粒球症 3:白血病
C:血小板、凝固因子の異常および出血性素因 1:血管因子の異常 2:血小板因子の異常 3:凝固因子の異常 4:薬剤による凝固障害
|
| GR:血液とその働き |
血液は、血球成分や血漿成分の機能により多彩な作用を営んでいる。
これらのうち、赤血球、白血球、血小板の働きが主なもので、ここではこれら3種の細胞について簡略に記載致します。
|
| 1:赤血球 (RBC:Red Blood Cell) |
正常数は、男性で約500万個/mm3、女性で約450万個/mm3位です。
寿命は約120日です。
大きさは7〜8μmで、楕円形をしています。
赤血球の生体における機能は、肺から末梢組織への酸素(O2)運搬です。
これを担う赤血球中のヘモグロビン(Hb)は、組織中よりCO2の運搬にも関与していいます。

|
| 2:白血球 |
白血球について
白血球には多くの種類があり、それらはすべて特有の機能を担っており,同一に論ずること出来ません。
しかし、これらの機能を概括すると生体防衛機能,とくに感染防御を担っているといえます。
そのため機能の場は、赤血球が血管内にとどまって働くのに対し、白血球では血管外組織となります。

1:好中球
白血球のうち70%以上を占めています。
侵入した病原菌や異物を貧食し,殺菌,消化し,無毒化するのが主要な役割です。
この時、好中球のもつ特殊顆粒およびリソソームに含まれる多くの酵素や殺菌物質が貧食空砲内に放出され、
殺菌、消化に働いています。.
また貧食時に生ずる活性化酵素は強い殺菌作用を発揮します。

2:好酸球
同様に貧食能を有していますが,その機能はあまり明瞭ではありません。
寄生虫に対する防御機能や、アレルギー作用に関与し,免疫複合体を取り込んだり、ヒスタミンなどを不活化すると
言われています。

3:好塩基球
機能は明らかではありませんが,同一細胞起源の組織肥満細胞はヒスタミン,ヘパリンなどのアレルギー反応に深く関与
していることが知られています。
4:リンパ球
免疫現象を担う最も主要な細胞群です。
白血球のうち25%ほどを占めています。
リンパ球を大別すると,胸腺由来のTリンパ球と、胸腺での影響をうけないBリンパ球とから成ります。
(1)T-細胞
細胞性免疫や、抗原の認識にはじまる免疫反応の指揮者的役割を果たしています。
Tリンパ球は,これらの免疫反応を促進するヘルパーT細胞やこれを抑制するサプレッサーT細胞などに細分されて
います。
@ヘルパーT細胞
Bリンパ球に働きかけて形質細胞に分化させ、抗体(免疫グロブリン)産出をさせます。
AサプレッサーT細胞
Bリンパ球の免疫グロブリン産生を抑制します。
BキラーT細胞
腫瘍細胞・ウイルス感染細胞を傷害します。
(2)NK細胞
腫瘍細胞・ウイルス感染細胞を傷害します。
(3)B-細胞
抗原が体内に侵入してくると、B細胞は、同一の抗原特異性をもつヘルパーT細胞、もしくは直接抗原により活性化
され、プラズマ細胞(形質細胞)へと変化し、抗体を産生・分泌するようになります。
免疫応答により体内から抗原が排除されると、プラズマ細胞は、メモリーB細胞となり、次に抗原が体内に侵入してきた
時に速やかに免疫応答を起こすために備えています。
5:単球
白血球のうち3〜8%を占めます。
白血球細胞の中で最も大きく(12〜18μm)、豆型の核を持っています。

単球は、感染に対する免疫の開始に重要であり、アメーバ運動を行って移動することができ、細菌などの異物を
細胞内に取り込み、細胞内酵素を使って消化します。 断片化した異物を、もともと細胞質内に持っていたクラスIIMHC分子と結合させ、細胞表面に提示し、これを
ヘルパーT細胞が認識します。
こうして免疫反応が開始されます。
また単球は血管外の組織や体腔に遊走し、そこで組織固有のマクロファージ(大食細胞)に分化します。
あるいは、単球とは血管内に存在しているマクロファージと考えることもできます。
寿命は血液中では10〜20時間、組織中では数か月〜数年です。
|
| GR-3:血小板 |
通常の血液中には、10万〜40万個/mm3程度含まれている。
寿命は3〜10日であり、寿命が尽きると主に脾臓で破壊されます。
主に止血に関与する重要な細胞です。

血管がなんらかの原因により損傷をうけ,血管内皮がはがれて内皮化の組織が露出すると,血管内では最も内皮に近い
周辺にそって流れている血小板はただちにその部分に粘着します。
コラーゲン線維や基底膜に粘着した血小板は,それ自身がもつADPやセロトニンを放出し,その影響をうけて周囲の
血小板は凝集をはじめ同時に血管も収縮します。
この反応は血液損傷後数秒以内に生ずることが知られています。
凝集は集まった血小板自身からのADPのほかに,周囲組織や赤血球からのADPも供給され,ますます大きく、
強くなります。 つぎに血小板から放出された血小板第3因子や損傷組織からの組織トロンボプラスチンが働いて血液中の
プロトロビンをトロンビンに転化し,これは血小板に働いて血小板粘性変態を起こさせることになります。

|
| 血液と口腔機能 |
口は、外界と体内の関所のような部位です。
病は口から入るのたとえがあるように、様々な病原微生物がここを通過しようとします。
しかし、唾液による防御作用や、味覚・触覚などによって、生体に危険を及ぼす物はここを通ることが出来ない様な
仕組みが備わっていて、生体を危険から守ることが出来ているのです。
しかし、後述する様に、血液の具合が悪くなれば、平滑舌、味覚障害、歯肉出血など様々な病気が発症し、防御機能、
嚥下機能、構音機能が損なわれる事態が発生してしまいます。
どの臓器でも同じですが、やはり口腔機能が十分に発揮されるためには、健全な血液の働きが必要不可欠であることが
お分かり頂けると思います。
|
| 参考資料 |
|